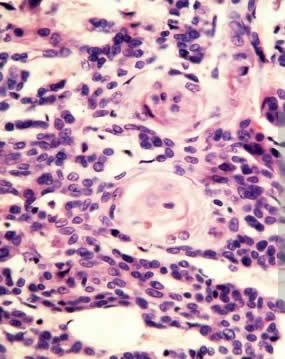
Qué es un epitelio y cual es su función

Qué es un epitelio y cual es su función
El epitelio es la capa que cubre las superficies de los vasos sanguíneos en el interior, las cavidades como el intestino y el estómago, estructuras como la vagina, el tubo uretral y partes externas como la piel.
Está formado por capas de células con polaridad (cargas eléctricas) lo que le confiere una cohesión y una funcionalidad especial, que establece intercambio con las estructuras o elementos con l
os que está en contacto (sangre, secreciones, electrolitos, agua, proteínas, grasas, etcc..).
El epitelio esta formado por una o mas capas de células unidas entre sin que recubren toda la superficie de las estructuras donde se encuentran. Las células de los epitelios representan mas del 60% de todas las células del organismo lo que lo convierte en una de las mas relevantes de las estructuras funcionales del organismo.
Cuando un epitelio desaparece pueden generarse células anormales en el sitio afectado dando origen a los tumores malignos, por lo que la conservación de su integridad es básica, en los sitios donde hay cambios de un tipo de epitelio a otro como en el cuello uterino, el esófago con el estómago, la uretra con el cuello de la vejiga son sitios donde por la transición y la velocidad de recambio de las células, puede escapársele al aparato inmunológico que se encarga de destruir las células anormales, una que genere cáncer.
La polaridad celular de los epitelios es la característica mas trascendente, las diferentes capas de células que van desde la mas superficial hasta la mas profunda tienen funciones, actividades y capacidades diferentes de interrelacionarse, con el medio, su composición de grasa y proteínas no es igual en la superficie, que en la capa intercontectora o que en la capa mas profunda o basal, sus estructuras intracelulares como el aparato de Golgi, los centrosomas y los cilios están ubicados de formas diferentes.
El comportamiento eléctrico de las células del epitelio esta determinada desde el nacimiento de un individuo y ligada a algunos genes, definiendo sus actividades y la forma de entrelazarse con las otras células, su capacidad de intercambio con las proteínas y la capacidad de identificar el esqueleto de los tejidos donde va a implantarse para darle la estructura tridimensional que ostentará, cada capa tendrá su código de polarización y no cambiará hasta el final de la vida.
Las uniones de los epitelios que tienen su fortaleza cohesiva en la membrana lateral de los mismos, gracias a su fuerza por la polaridad forma barreras protectores contra agresiones del medio.
Los complejos moleculares de polaridad son estructuras de moléculas evolucionadas que unidas participan como enlaces potentes entre las células, forman andamiajes para construir el esqueleto de los tejidos o citoesqueleto, también modulan el comportamiento de proteínas efectoras (que generan funciones como las de la inflamación) , de estos complejos se mencionan tres: Par, Crumbs y Scribble.
Debido a que cada tiene por genética definida su carga eléctrica y sus funciones es que se logra toda esta gama de actividades que convierten al epitelio en un sorprendente aparato multifuncional con repercusión en todo los que sucede en el organismo a cualquier nivel.
El esqueleto de los tejidos o citoesqueleto esta formado de microtúbulos elásticos que permiten la contractilidad, invaginación y retracción de los mismos. Los microtúbulos del citoesqueleto también permiten el transporte de proteínas, dan fuerza a la estructura y favorecen el movimiento de otras moléculas a través de sus ductos gracias a la polaridad de las cargas eléctricas en cada zona.
El crecimiento y conservación de los epitelios se debe a la presencia de células madre pluripotenciales que se autorenuevan, sin embargo, si su reproducción o renovación se ve alterada por procesos inflamatorios crónicos, agresiones químicas, o biológicas (virus) pueden mutar a una forma cuya progenie será anormal dando origen a los tumores malignos. La división de estas células madre está regida por la actividad eleéctrica del epitelio que se encarga de garantizar una simetría uniforme en este evento reproductivo que sin embargo puede ser alterada cuando la maquinaria de polarización del epitelio se ve modificada.
Al saber que los cambios de polaridad en el epitelio son la fuente del cáncer epitelial abre nuevas posibilidades de investigación para el diseño de tratamientos preventivos y curativos en oncología (rama de la medicina que se encarga de la prevención, diagnóstico y tratamiento de los tumores).
Bibliografía:
“Formación de Tejidos Epiteliales”. Martín B. F. Centro de Biología Molecular, Severo Ochoa CSIC, Madrid. Revista de Investigación Científica. Octubre 2011. Páginas: 13-15.